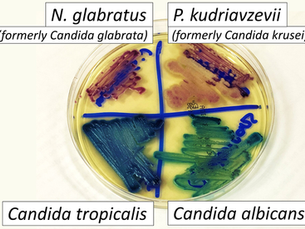
Machine Learning & Metabolism - Undergraduate project by Tanusree Chepuri

top of page
UNC Charlotte
All Posts


LaBella Lab Master's Student Snags Poster Award
On Monday September 15th members of the LaBella lab attended the 2025 Biomedical Sciences Symposium in Uptown Charlotte. Master's...
Abigail LaBella
Sep 231 min read
Decoding fungal metabolism with machine learning by Isabel Montoya
During the Spring 2025 semester, I had an incredible opportunity to work with Dr. LaBella on a research project exploring codon usage...
Abigail LaBella
Sep 93 min read


LaBella lab takes the Evolution conference by storm
The LaBella Lab and UNC Charlotte took the 2025 Tri-Society Evolution Conference by storm. UNC Charlotte had over 15 faculty, staff and...
Abigail LaBella
Jul 151 min read

Machine Learning & Metabolism - Undergraduate project by Tanusree Chepuri
I am Tanusree Chepuri, a 3rd year senior at UNC Charlotte majoring in Biology (BS), and minoring in Bioinformatics and Data Science. In...
Abigail LaBella
May 212 min read


Dr. LaBella awarded NIH Grant
Dr. LaBella was recently awarded the Maximizing Investigators' Research Award (MIRA R35) from the National Institute of General Medical...
Abigail LaBella
Oct 7, 20241 min read


BIOINFORMATICS PROFESSOR DISCOVERS SURPRISING EVOLUTIONARY PATTERN IN LANDMARK YEAST STUDY
UNC Charlotte recently featured our research on their website. https://inside.charlotte.edu/news-features/2024-04-26/bioinformatics-profe...
Abigail LaBella
Jun 18, 20241 min read


1,154 Yeast Genomes!
New work characterizes the genomes and evolution of 1,154 yeasts
Abigail LaBella
May 3, 20242 min read


New faces & farewell to graduates
This semester the LaBella lab says farewell to Colin Speer! Colin spent a little over a year in the lab while obtaining his Master's in...
Abigail LaBella
May 3, 20241 min read


Evolutionary Forces at Play for Non-Hodgkin’s Lymphoma
A research blog by Colin Speer Did you know that certain cancer-associated genetic mutations might have once provided us with an...
Abigail LaBella
Aug 21, 20235 min read


From Jane to Baine
In 1822 Jane Wright Earl was born in England. She subsequently moved to Utah where she had 13 children and was eventually the grandmother...
Abigail LaBella
Mar 27, 20234 min read


Catching up on LaB(ella) publications
The past few months have seen multiple publications from the LaBella lab members. Check them out below! Mitochondria of Aspergillus ->...
Abigail LaBella
Nov 22, 20222 min read


What is synteny anyway??
Wikipedia says that "Synteny is a neologism meaning "on the same ribbon". It's a term in genetics that refers to the level of similarity...
Abigail LaBella
Nov 9, 20221 min read


The Lab LaBella has arrived!
I am incredibly excited to start my lab here at UNC-Charlotte. The city, university, and my colleagues have been so welcoming! And... we...
Abigail LaBella
Sep 23, 20221 min read
bottom of page